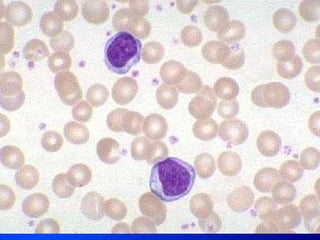
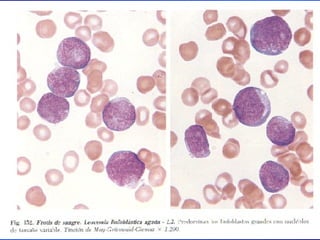
Leucemia Linfocitica Cronica B
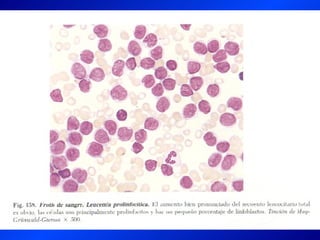
Leucemia Linfocitica Cronica B
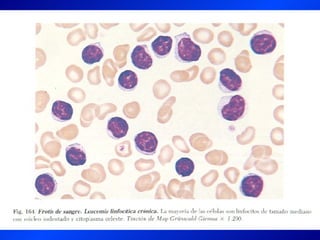
Leucemia Linfocitica Cronica B

Este documento describe el tratamiento y conceptos generales sobre el tratamiento de la leucemia linfocítica aguda y la leucemia linfocítica crónica. Incluye información sobre quimioterapia, radioterapia, transplante de médula ósea y tratamiento por etapas. También cubre medidas generales, de soporte y sintomáticas, y bases generales del manejo con quimioterapia.